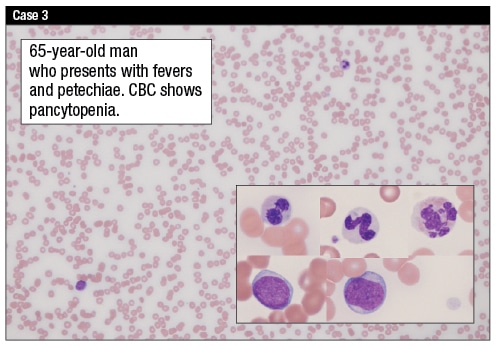
cytopeniasCase3

Karen Titus
April 2015—Think age is important only if you’re a Hollywood actress (unless you’re lucky enough to be Meryl Streep)? Think again.
Specifically, Joan Etzell, MD, wants pathologists to think about age-adjusted reference ranges for thrombocytopenia and neutropenia. They’re intrinsic to the basic definitions of these diseases, she pointed out in a course on peripheral cytopenias at last year’s AACC meeting.

Dr. Etzell, clinical professor, laboratory medicine, University of California San Francisco School of Medicine, and medical director, Sutter Health Shared Laboratory, Livermore, Calif., noted that pediatric patients can have different reference ranges than adults, particularly for neutrophils. “But the risk of complications in pediatric and adult patient populations is similar based on the absolute counts,” she said.
Looking at thrombocytopenia, it’s generally defined as a platelet count lower than the lower end of normal, which typically is 150 × 109/L (150,000/µL). Patients generally don’t get into trouble with bleeding complications until platelets drop below 50,000/μL, she said. At that point, patients who do have difficulties are likely to be those who’ve experienced a traumatic event or surgery. Not until platelet counts drop below 20,000/μL will patients exhibit noticeable hemorrhages, such as those in the skin and mucus membranes, as spontaneous hemorrhage unrelated to trauma or other intervention, Dr. Etzell said. And a platelet count of less than 10,000/μL can result in spontaneous life-threatening hemorrhage in, for example, the gastrointestinal tract or the central nervous system.
“These thresholds—10,000 or sometimes 20,000—are frequently used as transfusion thresholds,” Dr. Etzell said, with 50,000/μL used as a threshold for patients undergoing procedures. In cases in which patients are undergoing a CNS procedure, prophylactic platelet counts of up to even 100,000/μL may be used.
 Neutropenia typically is defined as an absolute neutrophil count (ANC) less than 1.5 × 109/L. “However,” she said, “as you would expect, the risk of infection varies by degree of neutropenia.” Mild neutropenia is defined as between 1.0 to 1.5 × 109/L; these patients have very mild risk of increased, but usually not serious, infection. Patients with moderate neutropenia—between 0.5 and 1.0 × 109/L—can usually be treated as outpatients, with oral antibiotics. When the neutrophil count falls below 0.5 × 109/L, severe infections can occur, which may require intravenous parenteral antibiotics, depending on the clinical situation.
Neutropenia typically is defined as an absolute neutrophil count (ANC) less than 1.5 × 109/L. “However,” she said, “as you would expect, the risk of infection varies by degree of neutropenia.” Mild neutropenia is defined as between 1.0 to 1.5 × 109/L; these patients have very mild risk of increased, but usually not serious, infection. Patients with moderate neutropenia—between 0.5 and 1.0 × 109/L—can usually be treated as outpatients, with oral antibiotics. When the neutrophil count falls below 0.5 × 109/L, severe infections can occur, which may require intravenous parenteral antibiotics, depending on the clinical situation.
Last but not least, pancytopenia is generally defined as the combination of anemia, thrombocytopenia, and neutropenia below age- and gender-specific reference ranges.
In her talk, Dr. Etzell asked her audience to consider a number of issues beyond reference ranges, of course. There is much for pathologists to ponder as they sort through etiologies, assessments, and diagnoses.
As with the anemias, the other cytopenias can be thought about in two broad categories to explain their causes: 1) decreased cellular production, or 2) increased cellular destruction. In the first category, Dr. Etzell said, there are plenty of factors that can lead to bone marrow suppression or even replacement, including medications and chemotherapy; infections, including uncomplicated viral infections and some granulomatous infections (think tuberculosis, other acid-fast bacteria, fungal infections); infiltrative processes, such as metastatic tumor; entities such aplastic anemia and paroxysmal nocturnal hemoglobinuria; and chronic illnesses.
Then there are situations that can result in ineffective hematopoiesis. Like a poorly trained workforce, cells are made, but not effectively enough to enter the peripheral circulation and serve their function. “This can include B12 and folate deficiency, where there is abnormality in DNA synthesis,” Dr. Etzell said. “Frequently, when you look in the bone marrow in these patients, the marrows will be quite cellular”—evidence that the cells are being produced but aren’t entering the peripheral circulation. A similar situation occurs with myelodysplastic syndrome, she continued: The cells show up but, like unsophisticated party guests, fail to circulate adequately.
In addition, cytopenias can result from increased cellular destruction, loss, or splenic sequestration. “So bleeding will result in anemia,” she said. And a variety of immune-mediated processes can result in thrombocytopenia, neutropenia, and/or anemia.
The reticulocyte count, or presence of polychromasia on the peripheral blood smear, can help assess bone marrow response to anemia. As Dr. Etzell noted, some of the newer CBC analyzers have a parameter for reticulated platelets, which is a measure of the younger platelets that are released into circulation. This, Dr. Etzell said, can help distinguish between thrombocytopenia that’s due to a peripheral destructive process or one due to decreased marrow production.
But the peripheral blood smear remains the mainsail of these patient workups.
“As we evaluate a peripheral blood smear, the first thing to do is to rule out pseudothrombocytopenia or an artifactual thrombocytopenia” that results from quirks in the way CBC analyzers count platelet particles. Platelet satellitism, which is uncommon, happens when EDTA-dependent antibodies cause platelets to stick to the surface of neutrophils. When this occurs, they won’t be counted as individual particles on their trip, through the CBC analyzer, resulting in a low platelet count. Likewise, giant platelets can create difficulties because platelet counting depends, to some extent, on particle size. The bigger the platelets, and the bigger their proportion of the platelet population, the greater the chance for the analyzer to underestimate their count. “Platelet clumping also doesn’t allow for adequate enumeration,” Dr. Etzell said.
Given all this, many laboratories set a threshold for smear review at 100,000/μL for first instance of thrombocytopenia, to rule out pseudothrombocytopenia. “In these cases, repeat samples may be useful.”
Assuming a case involves true thrombocytopenia, a number of peripheral blood findings can be useful in detecting underlying etiologies, including the presence of schistocytes; spherocytes or red cell agglutination; or atypical lymphocytes, neutrophilia, or toxic granulation. In addition to these signs of possible infection, it’s important to look for indicators of significant bone marrow abnormalities, including blasts, neutrophil dysplasia, nucleated red cells, or dacrocytes (teardrops).
Spherocytes or red cell agglutination may be associated with anemia, usually due to immune-mediated mechanisms and autoimmune hemolytic anemia. In the peripheral blood smear, there may be a large number of microspherocytes as well as nucleated red cells. Some patients may have autoantibodies to red cells; some may also have autoantibodies to platelets. “In these patients,” Dr. Etzell said, “testing for hemolysis—lactate dehydrogenase (LDH), bilirubin—may be useful.” A direct antiglobulin test to look for antibodies on red cell surface can detect an autoimmune hemolytic anemia.
White blood cell findings can also be useful for determining an underlying etiology in a thrombocytopenic patient, Dr. Etzell added. “As we’re looking at the peripheral blood smear, some of the morphologic features that can be helpful in tipping us off to infection is the presence of atypical or reactive lymphocytes, presence of neutrophilia or left shift in the neutrophil series, or presence of toxic granulation.”
Dr. Etzell showed several examples of neutrophils with increased or toxic granulation, as well as Döhle bodies. “These things aren’t entirely specific for infection; they can be seen with cytokine therapy, such as G-CSF therapy,” Dr. Etzell cautioned. Putting the morphological features into the clinical context is important.
Dr. Etzell also showed photomicrographs of uncommon, yet important organisms that can be identified on peripheral blood smears (Fig. 1). She recalled identifying organisms on the peripheral blood smears of a number of patients “when the clinician knew the patient had fever, but it wasn’t clear exactly what the underlying etiology was.”
Among the possible culprits, she noted, are histoplasmosis, which is a small, intracellular yeast form, uniform in size and most commonly seen in neutrophils. The morphology of another yeast organism, Malassezia furfur, resembles a bowling pin, Dr. Etzell said. This yeast thrives on lipid and is most frequently seen in patients who are on lipid-supplemented total parenteral nutrition.
It’s also possible to identify bacteremia on peripheral blood smear, though it’s not necessarily a common finding, Dr. Etzell said. The organism load is low, generally speaking, so, “We’d have to look at a lot of blood to find the bugs,” she said. When it does occur, it’s often in patients whose peripheral smear samples were taken from a catheter or an IV site that has been colonized by an organism. Even if that’s the case, it’s important to notify clinicians of the finding, Dr. Etzell said, because serious acute infectious complications can develop quickly, and the catheter may need to be removed.
Dr. Etzell advises keeping other causes of thrombocytopenia in mind. Many of these do not have specific blood smear findings but might be worth considering when delving into patient history.
Some, she said, are due to decreased platelet production. In this situation, platelets tend to be normal size on the peripheral smear. The cause can be chemotherapy, alcohol, radiation, some vaccinations, severe vitamin D deficiencies, a variety of congenital disorders, and certain nutritional deficiencies. “B12 and folate [deficiencies] come up repeatedly here because they can present as an isolated anemia, although if it continues to become worse and persists, it will result in lowering of the platelet count and neutrophil count.”

The other category, as Dr. Etzell mentioned, is increased platelet destruction.
For starters, there’s peripheral destruction due to an immune-mediated process, such as immune thrombocytopenic purpura. Certain drugs (heparin, quinine, valproic acid) can result in peripheral platelet destruction. Other causes of thrombocytopenia can include a dilutional effect—a trauma patient, for example, who receives a massive transfusion of red cells—and altered distribution, which can occur with splenomegaly. Then there are congenital abnormalities. “Particularly in children or in patients [who] have had lifelong thrombocytopenia, congenital thrombocytopenia should be considered,” Dr. Etzell said. This would include Wiskott-Aldrich (a syndrome in which the platelets tend to be very small) and May-Hegglin anomaly (with its giant platelets and Döhle body-like inclusions in the neutrophils). Fechtner, Epstein and Sebastian syndromes, which sounds like a law firm but isn’t, share similar morphologic features.
Dr. Etzell presented several case studies to show how to work up these patients.
The first involved a 70-year-old woman who lived in a skilled nursing facility. She presented with petechiae; a peripheral smear showed a platelet count of 42,000/μL, with some enlarged forms. Her physicians, suspecting immune thrombocytopenic purpura, started her on prednisone therapy. Two weeks later she returned to the hospital with fevers and pancytopenia. A review of the peripheral blood smear (Case 1) showed light purple inclusions, which are representative of human granulocytic anaplasmosis.
“In all likelihood,” said Dr. Etzell, “she had Anaplasma infection originally.” Once she was given steroids, the Anaplasma (previously referred to as Ehrlichia) was easier to see because of the suppressed immune response. The peripheral blood smear, in other words, is not a very sensitive way to pick it up. Those looking hard for it might find it only half the time in patients who have it, Dr. Etzell estimated. But it’s important to look. “These patients can undergo multisystem organ failure and die, and the therapy is simple antibiotic therapy.”
Clinical symptoms of anaplasmosis are vague and resemble the flu or a cold, and clinicians aren’t necessarily thinking about it as a potential diagnosis. Laboratory findings can provide other clues. “We need to be thinking about it,” Dr. Etzell said. Among the hints: leukopenia; thrombocytopenia; and elevated transaminases, LDH, and alkaline phosphatase; less often, there may be anemia and elevated creatinine. If there’s suspicion or significant likelihood, consider diagnostic modalities. “It is easier to find if you make a peripheral buffy coat smear, although this would not be my first recommendation on how to make this diagnosis,” she said. Serology, PCR studies, and immunostains can also be useful.
With neutropenia and peripheral blood smear evaluations, Dr. Etzell said, it’s important to rule out pseudoneutropenia, which can be caused by leukoagglutination. Vortexing samples can, in some cases, help get a more accurate white count.
Laboratories may encounter a number of neutrophil abnormalities on the peripheral blood smear, including neutrophils that are hypolobated, hypersegmented, or hypogranulated. While these abnormalities can be seen—though rarely—in infections, due to increased cytokine production, they’re more often due to medications or primary bone marrow disorders, such as myelodysplastic syndrome.
Dr. Etzell’s second case was a 56-year-old man who was two years post-orthotopic liver transplant (Case 2). “He’s receiving tacrolimus and mycophenolate mofetil for immunosuppression,” Dr. Etzell narrated, “and his CBC shows a white count of 2.6 [× 109/L], with 1.5 [× 109/L] neutrophils.
Hemoglobin is 8.9 [g/dL]. His MCV is 79 [fL], and his platelet count is normal.” Looking at a photomicrograph, Dr. Etzell noted two neutrophils that were single lobate, with almost a checkerboard condensed appearance to the chromatin—Pelger-Huët morphology, in other words.
Often patients with Pelger-Huët anomaly don’t present until they have difficulties due to other disorders, she said. “It can be later in life, but that wouldn’t explain the neutropenia.” These patients typically don’t have neutropenia. So what might explain this morphology? Possibly a myeloid neoplasm, including MDS or AML. Perhaps the patient had recent chemotherapy, or was on some other medication.
In this case, that last possibility proved to be the culprit: The patient was on two immunosuppressive drugs, as noted. The neutropenia and the morphologic changes resolved about four weeks after reducing the mycophenolate mofetil dose. “This is a fairly common phenomenon in patients receiving these medications,” Dr. Etzell said. And the peripheral smear can be a helpful way to identify the problem.
As with political disagreements on Facebook, the causes of neutropenia seem endless. Dr. Etzell ticked off additions to the list: some autoimmune disorders, collagen vascular diseases, isoimmune neutropenia (which can occur in the neonatal period); complement activation (such as with hemodialysis or ECMO); hypersplenism; and drug-induced (such as postchemotherapy). She also noted that severe neutropenia can be caused by medications—such as antibiotics, procainamide, clozapine—that create agranulocytosis in the bone marrow.
In another example, Dr. Etzell presented the case of a 65-year-old man with fevers and petechiae (Case 3). His CBC showed pancytopenia, and his peripheral smear showed just a few white cells. The red cells were spread out, confirming anemia. On higher power, after scouring the slide, Dr. Etzell said, “I was able to find a couple of blasts, which are always concerning on a peripheral blood smear and never a normal finding.” She also discovered abnormal neutrophils, including some hypolobulated, some hypogranulated, and some that tended toward the hypersegmented side.
Such findings raise the red flag for an underlying bone marrow problem. In this patient the bone marrow biopsy was very hypocellular. The blasts were between roughly four and five percent—not clearly elevated, but based on the peripheral blast count, concerns about a hypoplastic myelodysplastic syndrome remained. Dr. Etzell cautioned, however, that presence of blasts in peripheral blood isn’t always neoplasm-related; especially in children, they can be related to robust marrow recovery following a severe marrow-suppressive event.
When it comes to the highly complicated topic of myelodysplastic syndrome (MDS)—“This is a topic we could [discuss] for quite a while,” Dr. Etzell said—it’s helpful to have an understanding of what pathologists can expect to see. It’s characterized by ineffective hematopoiesis and is most frequently associated with anemia. Hemoglobin is usually less than 10 g/dL; it can also be associated with a decreased absolute neutrophil count of less than 1.8 × 109/L or a platelet count less than 100 × 109/L. Levels above these don’t exclude a diagnosis of MDS if definitive dysplasia or cytogenetic findings are present. MDS typically shows morphologic evidence of dysplasia in one or more myeloid lineages and has a significantly increased risk of transformation to acute myeloid leukemia, especially in the higher grade disease, Dr. Etzell said. MDS has an incidence of three to five per 100,000 individuals, with a slight male predominance; median age of occurrence is about 70 years. Some 10,000 new cases are diagnosed each year in the United States.
“I’m sure that many of you [who] evaluate patients for cytopenias receive evaluations to ‘rule out’ MDS in these patients—and I always think, If only it were that easy,” said Dr. Etzell.
In addition to the preceding diagnostic criteria, the presence of increased ring sideroblasts—greater than 15 percent—can also support an MDS diagnosis.
“Clonal cytogenetic abnormality is incredibly helpful, but it’s only present in about 50 percent of cases,” Dr. Etzell said. “But a clonal cytogenetic abnormality can be used as presumptive evidence of MDS even if dysplasia is lacking. If you have morphologic dysplasia that’s sufficient, and you’ve excluded other causes of dysplasia”—the aforementioned medications, chemotherapy, nutritional status, etc.—“you have morphologic dysplasia. You can make a diagnosis of MDS.”
Presence of increased blasts in blood or bone marrow can also be quite helpful in making an MDS diagnosis, though Dr. Etzell reminded her audience that pathologists need to be cautious not to use the blast count to support the diagnosis of a myeloid neoplasm in the setting of G-CSF therapy.
The typical approach to ruling out an MDS is to do a bone marrow evaluation with cytogenetics. Physicians commonly request FISH; Dr. Etzell said it’s most useful in cases with a suboptimal metaphase analysis. “It can detect up to 15 percent more abnormalities if for some reason you’re not able to get the 20 metaphases that you typically evaluate.” Apart from that, she said, FISH offers little added benefit.
“More recently, we’ve started doing microarray analysis, including SNP arrays, to look for clonal abnormalities to help a diagnosis of MDS,” she said. This is most useful in those 50 percent of cases that haven’t shown a cytogenetic abnormality. “But if suspicion of MDS is high, it may be worthwhile looking at a SNP array or other microarray.”
Dr. Etzell said flow cytometry has been “in evolution” over the last decade or two. Its use in diagnosing MDS is not widespread. “It’s not particularly sensitive in picking up abnormalities,” she cautioned, nor is it entirely specific. “But if you put flow in the hands of highly experienced flow labs with many, many myeloid markers and objective criteria, the sensitivity may be somewhere in the 70 to 90 percent range and the specificity about 90 percent. But,” she reiterated, “these are experts reviewing a large number of myeloid markers.”
Finally, said Dr. Etzell, “You can’t talk about pancytopenia without talking about aplastic anemia. Unfortunately, aplastic anemia doesn’t have specific blood findings,” though there may be mild red cell macrocytosis. Looking at bone marrow can be helpful; usually it will be almost entirely replaced with fat. “In my experience it’s often best to make a diagnosis of a markedly hypocellular marrow or refer to marrow aplasia with a comment, since diagnosis of aplastic anemia does require correlation with clinical findings.”
Patients with certain cytogenetic abnormalities, such as trisomy 8, have always been troubling to Dr. Etzell, since they don’t necessarily predict MDS-like behavior. Monosomy 7 is a different matter. “That’s MDS-like behavior, and those should be called MDS,” she said. It’s not clear how trisomy 8 will behave, though some will progress to something that looks like a more typical MDS. “I will often sign these out descriptively and comment on what the cytogenetic abnormality may mean,” she said.
For good measure, Dr. Etzell spoke about paroxysmal nocturnal hemoglobinuria (PNH), which can also result in pancytopenia. PNH is due to a lack of GPI anchored proteins such as CD55 and CD59, resulting in hemolysis (among other clinical complications). This can then evolve to a bone marrow failure syndrome that looks quite similar to aplastic anemia or a hypoplastic MDS. “Some postulate that PNH is a manifestation on the spectrum from aplasia to myelodysplasia,” she said, “since all of these entities can demonstrate a subset of PNH-like cells.
“I find these three entities, in some cases, can be difficult to definitively distinguish,” she continued.
For all the potential difficulties in diagnosing the underlying cause for neutropenia, thrombocytopenia, and pancytopenia, Dr. Etzell concluded with a refreshing bit of simplicity. Despite the many underlying etiologies, the peripheral smear gives pathologists a solid start. “I’d like to remind you to first exclude pseudothrombocytopenia and pseudoneutropenia before undertaking additional workup,” she said. “Sometimes it’s as simple as drawing another sample. Peripheral blood smear review for cytopenias can be incredibly useful. It’s really an eye into the bone marrow of what may be going on.”
[hr]
Karen Titus is CAP TODAY contributing editor and co-managing editor.
![]()

